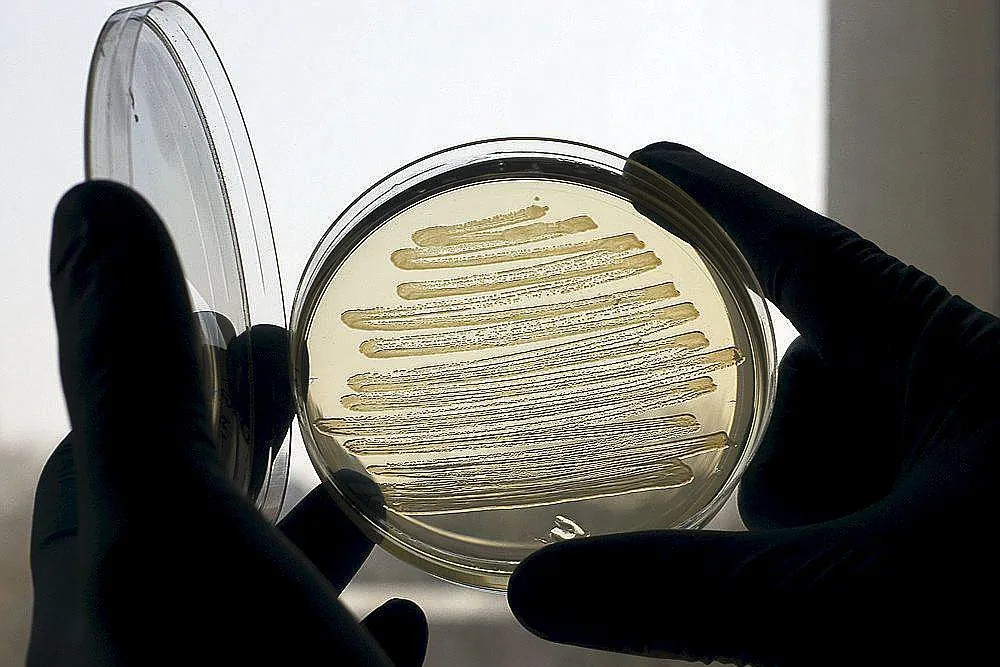
Primer caso de producción de paracetamol a partir de la bacteria  'Escherichia coli' utilizando una botella de plástico | Salud

Científicos británicos crean técnica para convertir plástico en paracetamol usando bacterias genéticamente modificadas.
Un equipo de investigadores de la Universidad de Edimburgo, Reino Unido, ha desarrollado una innovadora técnica que permite transformar residuos plásticos en paracetamol mediante bacterias modificadas genéticamente. El estudio, publicado el 23 de junio de 2025 en la revista Nature Chemistry, abre la puerta a una producción más sostenible de medicamentos y a una gestión revolucionaria de los desechos plásticos.
La investigación demuestra que la bacteria Escherichia coli puede convertir el ácido tereftálico —molécula derivada de botellas de PET, uno de los plásticos más comunes— en el ingrediente activo del conocido analgésico y antipirético.
El proceso, que ocurre en condiciones similares a la fermentación de cerveza, logra una conversión en menos de 24 horas con una eficiencia del 90 % (y hasta 92 % en condiciones optimizadas), trabajando a temperatura ambiente y con mínimas emisiones de carbono, a diferencia de la producción tradicional que depende del petróleo y genera gran contaminación.
Según Stephen Wallace, autor principal del estudio, esta técnica demuestra que “el plástico PET no es solo un residuo ni un material destinado a volverse más plástico: los microorganismos pueden transformarlo en productos valiosos, incluidos medicamentos”.





